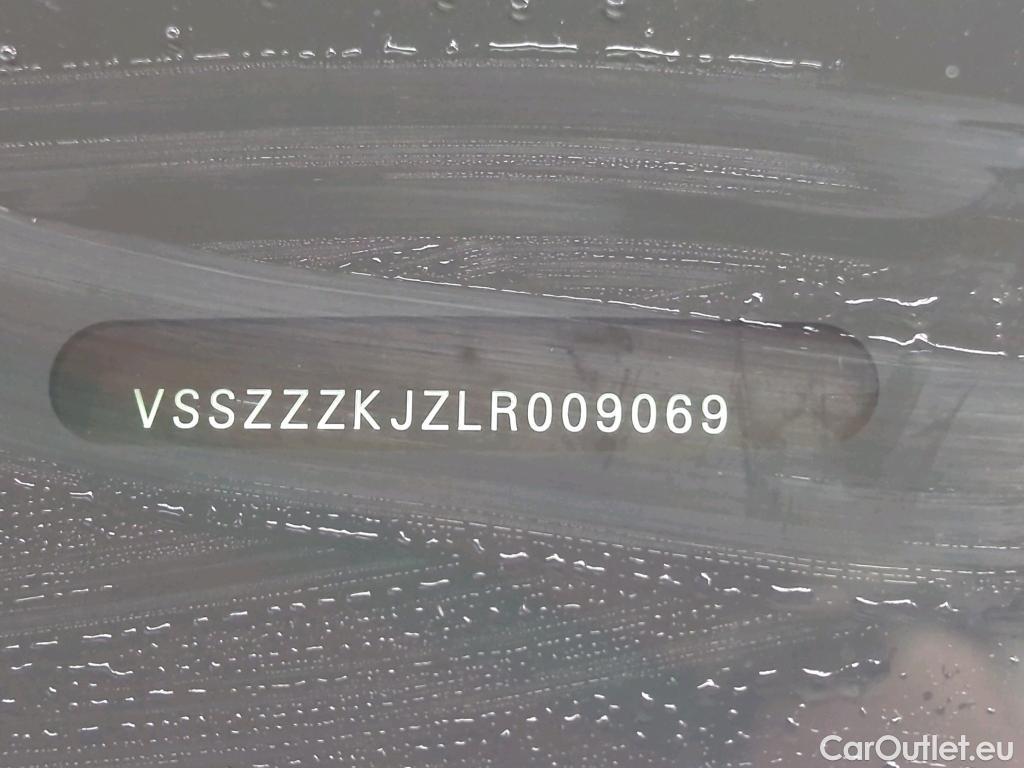

- Первая регистрация
- 01-09-2019
- Пробег
- 115 338 км
- Тип двигателя
- Дизель
- Объём двигателя
- 1598 куб. см
- Тип КПП
- МКПП (5 передач)
- Страна происхождения
- Германия
- Марка автомобиля, модель
- Seat Arona
- Модификация
- Style 1.6 TDI 70KW MT5 E6
- Мощность
- 70 кВт, 95 л.с.
- COВІemission
- 124
- Цвет
- Белый
- Тип кузова
- Кроссовер
- Количество дверей
- 5
Комплектация
- Ручной кондиционер
- Литые диски
- Датчики парковки
- Navigation system
- Heated seats
- Multifunction display screen
Achtung! Zum Fahrzeug sind uns Vorschäden in einer Gesamthöhe von ca. € 5014.82 netto gemeldet worden.Geschätzte Reparaturkosten von ca. 1903 € netto
- Первая регистрация
- 01-09-2019
- Пробег
- 115 338 км
- Тип двигателя
- Дизель
- Объём двигателя
- 1598 куб. см
- Тип КПП
- МКПП (5 передач)
- Страна происхождения
- Германия
- Марка автомобиля, модель
- Seat Arona
- Модификация
- Style 1.6 TDI 70KW MT5 E6
- Мощность
- 70 кВт, 95 л.с.
- COВІemission
- 124
- Цвет
- Белый
- Тип кузова
- Кроссовер
- Количество дверей
- 5
Комплектация
- Ручной кондиционер
- Литые диски
- Датчики парковки
- Navigation system
- Heated seats
- Multifunction display screen
Achtung! Zum Fahrzeug sind uns Vorschäden in einer Gesamthöhe von ca. € 5014.82 netto gemeldet worden.Geschätzte Reparaturkosten von ca. 1903 € netto
Похожие лоты из других аукционов
-

Seat Arona Style 1.6 TDI 95CV BVM5 E6 -

Seat Arona Xcellence 1.0 TSI 95CV BVM5 E6dT -

Seat Arona Style 1.0 TSI 95CV BVM5 E6dT -

Seat Arona SEAT / 2021 / 5P / todoterreno 1.0 TSI 85kW (115CV) DSG Style XL(SP) -

Seat Arona SEAT / 2017 / 5P / todoterreno 1.0 TSI 70kW (95CV) Style Edition Eco (CX) -

Seat Arona SEAT / 2017 / 5P / todoterreno 1.0 TSI 81kW (110CV) Style Plus (AC)